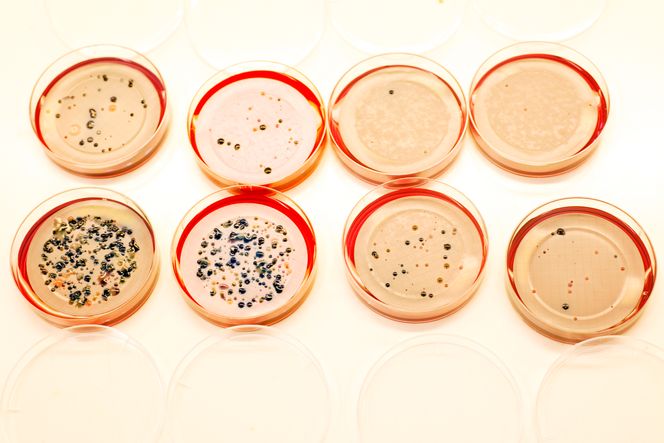
Medisinerte bakterier: Bakteriene nederst til venstre har ikke blitt utsatt for antibiotika, mens man kan se hvordan de andre opptrer når de blir «medisinert».

Det er en av de største truslene mot det moderne helsevesenet og menneskeheten som sådan – et globalt problem som ikke lar seg stoppe av landegrenser og andre barrierer.
Legevitenskapens kanskje viktigste oppfinnelse kan om ikke altfor mange år være nær verdiløs. Konsekvensene kan bli enorme dersom antibiotika ikke lenger virker mot de vanligste bakterieinfeksjonene.
Ekspertene ved NMBU Veterinærhøgskolen samarbeider nå med forskere i flere europeiske land om å se hvordan kloakken kan være en viktig kilde til antibiotikaresistente bakterier.
Tester resistens
På bordet foran seg har overingeniør Tina O’Sullivan fire runde skåler med bakteriefiltre. Avløpsvann fra det store renseanlegget i fjellet ved Bjerkås, som mottar avløpsvann fra over 600.000 personer i Oslo, Bærum og Asker, har blitt silt gjennom filtrene.
Så har bakteriekoloniene fått vokse videre i 37 graders temperatur.
Forskerne tester hvordan antibiotika virker på bakteriene. De ulike bakteriene fra Vestfjordens Avløpsselskap (Veas) har fått forskjellige fargekoder.
– De blå koloniene viser E-coli, forklarer Tina O’Sullivan.
Skålene viser tydelig hvordan bakteriefloraen reagerer på ulike typer antibiotika. Mens skålen som utsettes for amoxicillin og tetrasykliner har en relativt frodig vekst av bakterier, sliter bakteriene med å overleve i møtet med ciprofloxacin.
Sistnevnte er et såkalt reserveantibiotikum, en siste utvei som norske leger helst bare bruker dersom ingenting annet virker.

Sykehusproblem
De første tilfellene av «smittsom» resistens mot antibiotika ble oppdaget allerede på slutten av 50-tallet. Japanske eksperter så hvordan visse dysenteribakterier ikke lot seg knekke av antibiotika.
Forskernes oppmerksomhet har siden vært rettet mot sykehusbakterier, ettersom det er der man gjerne oppdager at enkelte pasienter ikke lar seg behandle lenger.
Ekspertene har sett på hvordan man skal hindre smitte mellom mennesker, men ikke fullt så mye på hva som skjer med bakterier og antibiotika når de forlater pasientene.
Forsker Henning Sørum forklarer hvordan vannklosettene på sykehusene kan være starten på en runddans med farlig utfall.
Kloakken fra norske sykehus går nemlig rett ut i det vanlige avløpssystemet. Renseanleggene tar totalt sett livet av over 99 prosent av bakteriene. Men den siste knappe prosenten er utfordringen.



Kloakkbakterier
Forskerne mener de har god grunn til å tro at sykehuskloakkens ferd gjennom rør og renseanlegg bidrar til å utvikle resistente bakterier.
Mesteparten av resistensen oppstår i naturen, og mikrobene har utviklet resistensgener til alle tider. Sopp og bakterier har brukt det vi i dag kjenner som antibiotika til å beskytte seg eller forsvare sin nisje.
I kloakken fra sykehusene er det imidlertid spesielt høye konsentrasjoner av både antibiotika og resistente bakterier.
– De mikrobene som kommer i nærheten av en høy konsentrasjon av antibiotika må forsvare seg, ellers sliter de. Har de ikke egne resistensgener, forsøker de å skaffe seg dette, slik at de kan overleve med mye antibiotika rundt seg, sier Sørum.
Miljøet i avløpssystemet fører sannsynligvis til en økning i trafikken av resistensgener mellom bakteriene.
– Kanskje hopper genet over til bakterier som hittil ikke har hatt resistens og smitter mennesker via for eksempel badevann, sier Sørum.
Særlig visse typer antibiotika som kinoloner kan ligge lenge i kloakken. De kan således påvirke mikrobene over lang tid.
Ofte kan vannet som går ut i fjorden være helt rent for bakterier. Likevel kan arvestoffet til de resistente bakteriene bli med ut i fjorden i form av usynlige DNA-tråder.
Disse kan igjen plukkes opp av andre bakterier i naturen.
Separate renseanlegg
Ekspertene har diskutert flere løsninger. En av løsningene har vært å destruere sykehuskloakk lokalt.
– Det kan for eksempel være aktuelt å forbrenne kloakken herfra, sier Sørum.
Løsningen har vært drøftet i forbindelse med byggingen av flere av de nye sykehusene her i landet. Som forsker har Sørum anbefalt separat avløpshåndtering for infeksjonsavdelingene på både St. Olavs Hospital i Trondheim og Sykehuset i Nordland. Så langt har ingen av sykehusene gjort alvor av dette.
Sørum har forståelse for at man har kviet seg for å investere i egne renseanlegg for sykehusene, siden forskningsresultatene fortsatt er noe svake.
– Dersom man bruker for mye penger, og det senere viser seg at faren var overdrevet, blir det vanskeligere å få støtte for å gjøre tiltak mot antibiotikaresistens i neste omgang, tror Sørum.

Massive data
At det er forholdsvis stor usikkerhet, og til dels uenighet, om bakterienes oppførsel i renseanleggene, viser en dansk undersøkelse.
Undersøkelsen avviste at kloakken har en sentral rolle som drivhus for de farlige bakteriene. De norske forskerne, og flere med dem, mener at danskene trolig tar feil.
Sørum viser til at et renseanlegg har en enorm flora av bakterier som skal bryte ned organisk materiale før avløpet går ut i sjøen.
– Disse bakteriene dominerer så mye i antall at det er vanskelig å finne de resistente bakteriene, sier forsker Sørum om de danske resultatene.
Moderne sekvenseringsteknologi gjør at forskerne sitter igjen med enorme mengder informasjon om arvestoffet til de ulike bakteriene i renseanlegget. Alt av levende liv kommer ut i bokstaver.
– Teknologien har gått så raskt frem at vi ofte ikke har oppdatert programvare og kunnskap til å forstå og anvende dette optimalt. Man klarer ikke alltid å sortere ut det viktigste i den enorme mengden med sekvenser. De resistente bakteriene behøver ikke være mange, men det de gjør kan få store konsekvenser.
Trykk på forskningen
Trolig vil svarene bli ganske mye klarere når forskerne ved NMBU Veterinærhøgskolen og deres kollegaer i syv andre europeiske land er klare med resultatene fra «Surveillance and limitation of antibiotic resistance in sewage» om en god stund.
Forskerne tar ut prøver fra avløpsanleggene på samme dag og samme tidspunkt. Så sammenligner de resultatene seg imellom.
Målet er å se hvordan landenes antibiotikabruk påvirker utviklingen av resistens. Det europeiske prosjektet skal også se om selve renseprosessene har betydning for resultatene.
I et annet prosjekt skal Veas sammen med Rikshospitalet og Bærum kommune studere avløpsnettet i Oslo-området, for å finne konkrete punkter hvor man mest effektivt kan gjøre tiltak mot spredning av antibiotika.
– Selv om vi i Norge bruker lite antibiotika, og sparer antibiotika til tilfeller der det virkelig trengs, hjelper det vel ikke så mye. Med dagens globalisering, vil det vil bli en bakteriesuppe uansett?
– Det vil lett bli en suppe, med den store transporten av matvarer, folk og dyr som skjer i dag. Biologisk får du en stor likhet etter hvert. Man må gjøre ting globalt, men det Norge kan gjøre er å vise vei, sier Sørum.









